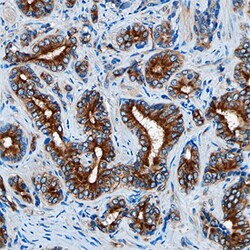

Promotional price valid on web orders only. Your contract pricing may differ. Interested in signing up for a dedicated account number?
Learn More
Learn More
Human DAB2 Antibody, R&D Systems™


Mouse Monoclonal Antibody
Supplier: R&D Systems MAB8064SP
This item is not returnable.
View return policy
Description
DAB2 Monoclonal specifically detects DAB2 in Human samples. It is validated for Western Blot, Immunohistochemistry, Immunocytochemistry.Specifications
| DAB2 | |
| Monoclonal | |
| LYOPH | |
| Western Blot 1 ug/mL, Immunohistochemistry 8-25 ug/mL, Immunocytochemistry 8-25 ug/mL | |
| P98082 | |
| DAB2 | |
| E. coli-derived recombinant human DAB2 Lys630-Ala770 Accession # P98082 | |
| 25 μg | |
| Primary | |
| Detects human DAB2 in ELISA and Western Blot. | |
| Human | |
| Purified |
| Western Blot, Immunohistochemistry, Immunocytochemistry | |
| 883216 | |
| Unconjugated | |
| Lyophilized from a 0.2 μm filtered solution in TBS with Trehalose. *Small pack size (SP) is supplied as a 0.2 μm filtered solution in PBS. with No Preservative | |
| Differentially-expressed protein 2, disabled (Drosophila) homolog 2 (mitogen-responsive phosphoprotein), disabled homolog 2, mitogen-responsive phosphoprotein (Drosophila), Disabled-2, DOC2, DOC-2DOC2disabled homolog 2, FLJ26626, mitogen-responsive phosphoprotein | |
| Mouse | |
| Protein A or G purified from hybridoma culture supernatant | |
| RUO | |
| 1601 | |
| Reconstitute at 0.5 mg/mL in sterile PBS. | |
| Use a manual defrost freezer and avoid repeated freeze-thaw cycles. 12 months from date of receipt, -20 to -70 degreesC as supplied. 1 month, 2 to 8 degreesC under sterile conditions after reconstitution. 6 months, -20 to -70 degreesC under sterile conditions after reconstitution. | |
| IgG3 |
Product Content Correction
Your input is important to us. Please complete this form to provide feedback related to the content on this product.
Product Title
For Research Use Only
Spot an opportunity for improvement?Share a Content Correction